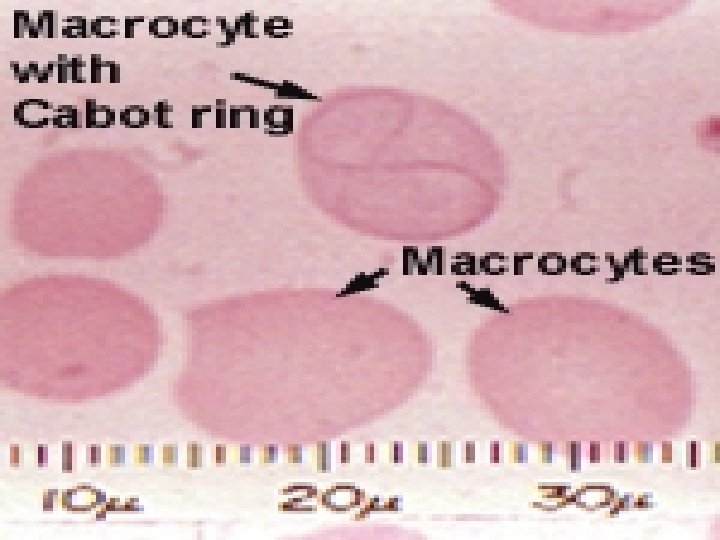
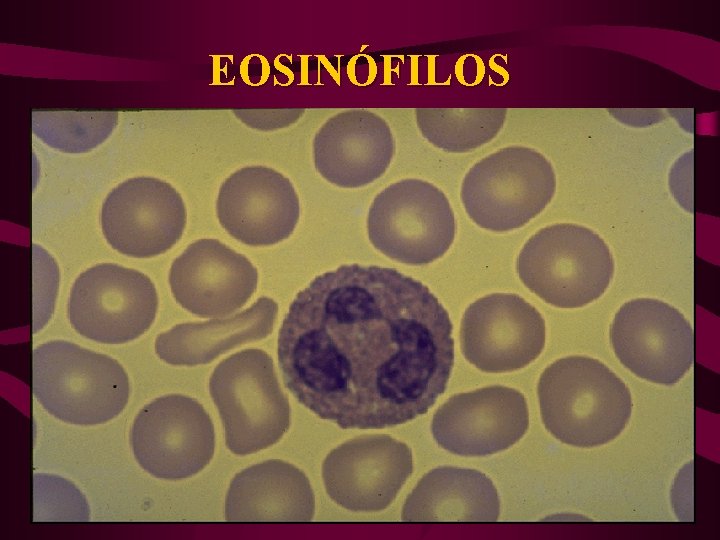
EOSINÓFILOS

TEJIDO SANGUNEO INTRODUCCIN La sangre es un tejido

- Slides: 71
TEJIDO SANGUÍNEO
INTRODUCCIÓN • La sangre es un tejido conectivo especial líquido que tiene gran importancia fisiológica ya que en ella se encuentran células y sustancia importantes para la vida. • Este liquido es de color rojo en las arterias por la presencia de oxigeno y de color azul en las venas por la gran concentración de CO 2
CARACTERISTICAS DE LA SANGRE 1. 2. 3. 4. 5. 6. 7. Volumen: 4 a 4. 5 litros en mujeres y 5 a 5. 5 litros en hombres. Densidad: 1, 600 en el plasma 1, 024 mg/ml. Color: Rojo en arterias(O 2), azul en venas(CO 2). Saturación de O 2: 97 -100% Saturación de CO 2: 40 -60% p. H: 7. 4 +/- 0. 04 (7. 36 -7. 44). Velocidad de Eritrosedimentación Globular: Es la medida de la velocidad de caida de los elementos formes al fondo del tubo de ensayo. Su valor varia según el método, el más usado es el método de Wintrobe para el hombre 0 -5 mm/hora y para la mujer de 015 mm/hora.
FUNCIONES DE LA SANGRE • 1. 2. 3. 4. 5. 6. 7. La sangre puede cumplir las siguientes funciones: Función respiratoria o transporte de gases Función nutritiva Función excretora Protección del organismo Regulación de la tempetura corporal Regulacion del equilibrio ácido-básico hemostasia
PARTES DE LA SANGRE PLASMA: parte líquida, corresponde el 5% del peso corporal y el 55% del volumen de sangre. Presenta: Agua: 95% SANGR E Solutos: 5%: glucosa, lípidos, proteínas(albumina, globulinas), enzimas, hormonas, sales minerales, iones(Na, K, Mg, Ca, Fe, etc), úrea, vitaminas hidrosolubles y liposolubles. ELEMENTOS FORMES: parte sólida de la sangre, corresponde el 3% del peso corporal y el 45% del volumen de sangre(hematocrito), aquí se encuentran los elementos figurados. Así tenemos: Eritrocitos: 7 -8 um Leucocitos: 7 -20 um Trombocitos: 2 -3 um
HEMATOPOYESIS • Proceso de formación de los elementos formes del sangre. En el adulto la mayor parte de los leucocitos y la totalidad de los eritrocitos y trombocitos se forman en la médula ósea. • Se calcula que una persona de 70 kg cada día se producen un trillon de células, incluyendo 200 billones de eritrocitos y 70 billones de leucocitos neutrófilos. • Este proceso de renovación de células se debe a que existe una célula llamada célula madre pluripotente hematopoyetica o STEM CELL que forma la M. O. R.
CÉLULAS DE LA MÉDULA ÓSEA
CHT = célula totipotencial hematopoyética. UFC= unidad formadora de colonias. UFB = unidad formadora de brotes. BI= blastos. LM = linfoide mieloide. GEMM = granulocitos, eritrocitos, monocitos, megacariocitos. L = linfoide. EG = eritrocitos y granulocitos, megacariocitos. M = monocitos. G = granulocitos. Meg = megacariocitos. Bas = basófilos. Eo = eosinófilos. LB = linfocitos B. LT = linfocitos T. LGG = linfocitos
FASES DE LA HEMATOPOYESIS 1. Periodo Mesoblástico: • • • Se da en el saco vitelino a partir de 16 a 19 días Se forman lo islotes hemagiogenos de Wolf Pander(que forman las paredes de los 1 eros vasos) y las células sanguineas primitivas, los hemocitoblastos. Es intravascular Casi todas las células formadas son eritrocitos nucleados y gigantes(180 fl) y sintetizan hemoglobina fetal. Termina entre la 10 a 12 semana de gestación.
FASES DE LA HEMATOPOYESIS 2. Periodo Hepático: • • • Inicia a las 5 semanas de gestación. Adquiere mayor importacia del 3 er al 6 to mes de gestación. Es extravascular Aparacen eritrocitos anuclados y macrociticos Tiempo de vida madia algo mayor
FASES DE LA HEMATOPOYESIS 3. Periodo Óseo: • • • Se realiza en la MOR a partir de 4 to a 5 to mes de gestación y a partir de 6 to mes es el principal lugar de la hematopoyesis. Los eritrocitos son anuclados y normociticos. Su tiempo de vida es mucho mayor
HEMATOPOYESIS • La hematopoyesis se realiza gracias una hormona que se fabrica en el hígado, esta es la hematopoyetina, además la hematopoyesis es el fenómeno general que se puede dividir en eritropoyesis, leucopoyesis y trombopoyesis.
GLOBULOS ROJOS • • Número: – Damas: 4. 5 millones/ml. – Varones: 5 millones/ml Forma: biconva(picarón) Anuclado Tiempo de vida 120 días Color: rojo(Hb) Función: tranportar O 2 y CO 2. Lugar de nacimiento: MOR. Dimensiones: – – Diámetro: 7. 5 um Espesor: 2. 6 um a 0. 8 um Volumen: 85 -95 fl Superficie: 135 um 2
GLOBULOS ROJOS • La célula a perdido ribosomas y mitocondrias y no puede sintetizar proteínas y depende únicamente de la glucólisis anaerobia para obtenergía; sin embrago, la célula contiene la maquinaria metabólica necesaria para mantener la integridad de su membrana superficial para conservar el hierro en la forma ferrosa y para impedir la degradación oxidativa de su Hb durante 120 días que dura su vida.
GLOBULOS ROJOSALTERACIONES 1. Poiquilocitos: formas patologicas en hoz pero ovaladas
GLOBULOS ROJOS ALTERACIONES 2. Drepanocito: arrugadoscon diametro de 7, 5 um y 2 um de espesor.
GLOBULOS ROJOS ALTERACIONES 3. Corpusculos de Howell. Jolly: son restos de Jolly: cromatina que se tiñen de color rojo violeta, se trata de uno o varios pequeños corpúsculos esféricos constituyen signo de inmadurez y aparece en algunas anemias hemolíticas, leucemias y talasemias
GLOBULOS ROJOSALTERACIONES 4. CUERPOS ANULARES DE CABOT: SON RESTOS DE CABOT: LA MEMBRANA CELULAR QUE SE DISPONEN COMO ANILLO O EN FORMA DE 8 Y TOMAN COLOR ROJO VIOLETA. SE LES OBSERVA EN LAS ANEMIAS GRAVES COMO LA PRODUCIDA EN LA INTOXICACIÓN POR PLOMO
OTRAS ALTERACIONES • • • Microcito: menor de 7, 5 um Macrocito: mayor a 7, 5 um Anisocitos: diametro variable Talasemias: La talasemia es un trastorno hereditario que afecta a la producción de hemoglobina normal. • La talasemia incluye muchas formas diferentes de anemia. La gravedad y el tipo de anemia depende del número de genes que estén afectados. • Este trastorno es común en las poblaciones de la costa del Mediterráneo, África y el sudeste asiático. La señal y síntoma que se presenta en todas las formas de talasemia es la anemia (deficiencia de glóbulos rojos), en varios grados, desde leve a grave.
ERITROPOYESIS • Es el proceso de formación de los glóbulos rojos, este proceso se estimula gracias una hormona llamada eritropoyetina, que es una glucoproteina producida por las células intersticiales peritubulares del riñon y que se eleva en procesos de hipoxia o hemorrágia profusas.
Eritropoyesis-Proeritroblasto • Es la célula más inmadura de la Su tamaño es grande (20 -25 um) con un núcleo redondo central de gran talla que ocupa la mayor parte de la célula, por lo que la relación nucleocitoplasmática es elevada. La cromatina muestra una estructura finamente reticulada, y posee uno o dos nucleolos mal limitados. El citoplasma es intensamente basófilo debido a su gran riqueza en polirribosomas, y queda reducido a una delgada franja perinuclear en la que se aprecia una zona más clara, de forma semilunar, que corresponde al centrosoma de la célula. En ocasiones presenta unas protusiones citoplasmáticas a modo de casquetes bastante característicos de estadio madurativo. En condiciones normales está desprovisto de inclusiones y vacuolas.
Eritropoyesis-Proeritroblasto
Hematopoyesis-eritroblasto basófilo • Es una célula de menor tamaño que su precursor (16 -18 um), y al igual que él posee un núcleo central, pero cuya cromatina es algo más madura, observándose algunas condensaciones cromatínicas que ocultan el nucleolo a nivel óptico. El citoplasma todavía tiene un color basófilo intenso. La relación nucleocitoplasmática disminuye progresivamente debido al rápido descenso del tamaño nuclear.
Eritropoyesis-eritroblasto policromático • Tiene un tamaño inferior (8 -12 um) y un núcleo redondo y central, cuya cromatina está fuertemente condensada, tal como corresponde a una célula madura. La relación nucleocitoplasmática alcanza el 25%. El citoplasma, en el que se ha iniciado poco a poco la síntesis hemoglobínica, va perdiendo basofilia y adquiere una tonalidad gris rosada, acidófila, conferida por la hemoglobina. Es la última célula eritroblástica con capacidad mitótica.
• Eritropoyesis-eritroblasto Ortocromático o Eritroblasto Acidofilo Tiene un tamaño pequeño (7 -10 um, con núcleo intensament picnótico y cromatina muy condensada de aspecto homogéneo. El citoplasma muy acidófilo va aumentando su contenido hemoglobínicohasta adquirir la tonalidad propia del hematíe maduro. Este eritroblasto no posee capacidad mitótica, aunque puede sintetizar proteinas y hemoglobina. El núceo, una vez finalizada su maduración, es expulsado de la célula por un mecanismo no del todo conocido, siendo éste posteriormente fagocitado por las células del sistema mononuclear fagocítico de la médula ósea.
HEMATOCATERESIS • Se refiere a la destrucción de los glóbulos rojos luego de finalizado su ciclo de vida. El envejecimiento y la muerte de los eritrocitos se produce en función de su edad, pero no se conoce el cambio molecular que determina la muerte del glóbulo rojo normal. • En los seres humanos su tiempo de vida es de 120 días en los ratones 40 en la llama 225, en los sapos 600 y en la tortuga 1400 días. • En condiciones fisiologicas, la destrucción de los hematies se produce en los macrófagos de, principalmente a nivel del bazo, hígado y Médula Ósea. • No se conocen bien los factores que intervienen en la identificación y secuestro de los eritrocitos envejecidos. Se pienza que podria estar relacionado las alteraciones que sufre la membrana cuando la maquinaria del eritrocito no puede mantener su integridad.
HEMOGLOBINA • Es una proteina casi esférica con un peso molecular de 64 500 Dalt y un diámetro de 6 nm. Consiste en un tratamero de cadenas polipeptídicas, 2 cadenas alfa y 2 beta de 141 y 146 aminoácidos respectivamente identicas 2 a 2 y que lleva cada un átomo de hierro en el centro de su núcleo porfirinico el grupo HEM • Hb= HEM + globina • HEM= protoporfirina IX +Fe 2+
HEMOGLOBINA
GRUPO HEM
HEMOGLOBINA • Los valores normales de hemoglobina son: 1. En varones: 14+-2 mg% 2. En damas: 13+-2 m% Nota un globulo rojo puede llevar hasta 4 moleculas de O 2 o de CO 2.
HEMOGLOBINA • Transporta el 97% de O 2 bajo la forma de oxihemoglobina, cada gramo de Hb transporta 134 ml de O 2 • Transporta el 20 – 40% del CO 2 en forma de carboxihemoglobina • Regula el equilibrio ácido base ya que actua como buffer, esta función la cumple ya que amortigua la acumulación de H+ previniendo la acidosis.
• • CATABOLISMO DE LA HEMOGLOBINA Después de los 120 días, los glóbulos rojos son destruidos y la hemoglobina queda libre. La globina es reduciada a sus aminoácidos constituyentes, y el hemo sigue las siguientes etapas: Etapa del sistema retículoendotelial: en las células del SER existe un sistema multienzimático hemo-oxigenasa, en el cual participan el oxigeno y el NADPH. El Fe+2 se oxida a Fe+3, y el C del puente metilo a CO. El Fe+3 se separa y forma biliverdina, que luego es reducida a bilirrubina por acción de la biliverdina reductasa. Transporte de bilirrubina en sangre: la bilirrubina se une a la albúmina, siendo este complejo NO ultra filtrado por el riñón. Etapa hepática: los hepatocitos captan la bilirrubina en sangre, dentro del hepatocito se conjuga la bilirrubina con ácido glucurónico, por acción de la UDP-glucuronil-transferasa, formando diglucurónido de bilirrubina o BILIRRUBINA DIRECTA, que es soluble en medio acuoso y se elimina por la bilis. La bilirrubina es llamada INDIRECTA, cuando sale del SER. En sangre solo existe bilirrubina indirecta y no se excreta por orina. Etapa intestinal: al llegar la intestino el diglucurónido de bilirrubina es hidrolizado, y la bilirrubina sometida a reducciones. Se forma mesobilirrubinógeno y finalmente a estercobilinógeno, que se oxida y forma la estercobilina que es la responsable del color de la materia fecal. Ciclo enterohepático: parte de los productos derivados de la reducción de la bilirrubina, son reabsorbidos y llevados de vuelta al hígado, donde se generará nuevamente diglucurónido de bilirrubina, que se excreta de nuevo con la bilis. Parte de los pigmentos reabsorbidos del intestino, pasan a circulación general y se eliminan por el riñón como urobilinógeno, el cual se oxida a urobilina. El aumento de bilirrubina en sangre es un signo observado en distintos cuadros patológicos, produciendo un tinte amarillo en la piel denominado ictericia.
ANEMIA • Definición funcional: disminución de la capacidad de la sangre para transportar oxígeno a los tejidos lo que provoca hipoxia tisular. • Reducción por debajo de los límites normales de la masa total de hematíes circulantes; como análogo se mide el hematocrito y la hemoglobina.
Anemia sideroblastica
Cuadro clinico – Síntomas • Fatiga • Debilidad muscular • Cefalea • Vértigo • Síncope • Disnea • Palpitaciones - Signos Esplenomegalia Hepatomegalia Palidez en la piel y conjuntivas Hipotensión Ictericia Deformidades óseas en anemias congénitas Lengua lisa Disfunción neurológica
Dedos en forma palillo de tambor y uñas en forma de lunas de reloj Glositis por anemia ferropénica La anemia ferropénica produce una atrofia de las mucosas especialmente del dorso de la lengua que se queda sin papilas dando un aspecto liso, brillante y rojizo a ésta. Cuando se combina con disfagia se habla del Síndrome de Paterson-Kelly o Plummer-Vinson palidez
Palidez de las palmas
CLASIFICACIÓN DE LAS ANEMIAS • • Clasificación Morfológica Se basa en tamaño promedio y concentración de Hemoglobina de los eritrocitos según lo indican los índices eritrocitarios. – – – • Macrocítica normocrómica Normocítica Normocrómica Microcítica Hipocrómica Clasificación Funcional – – Defectos proliferativos: es el que produce las anemias relacionadas con malignidades, enfermedades renales crónicas y ciertas endocrinopatias. Defectos de maduración (eritropoyesis ineficaz) – Defecto de supervivencia (aumento de destrucción por hemólisis y hemorragia) • • Se perturba el proceso nuclear o citoplásmico Alteraciones intrínsecas de los eritrocitos – – • Alteraciones extrínsecas de los eritrocitos – – • • Trastornos de síntesis de Hb Trastornos enzimáticos y de membrana de los eritrocitos Mediada por anticuerpos Infecciones como paludismos Agentes químicos Anemias carenciales: – – Por falta de Fe Por falta de folatos
GLOBULOS BLANCOS O LEUCOCITOS • Celulas de la sangre que emiten seudópodos y que se pueden desplazar a zonas donde hay inflamación , infección o alergia. • Numero: 5000 -10000 gb/ml. • El aumento se denomina leucocitosis • La disminución leucopenia • Forma: circular • Tamaño de 7 a 20 um • Tiempo de vida: • Neutrofilos: 6 -12 horas. • Linfocitos: 100 -200 días.
LEUCOCITOS • Su función es la defensa del organismo a traves de 4 propiedades: 1. Quimiotaxis: movimiento orientado a un lugar en Quimiotaxis: especial mediado por las sutancias quimiotacticas, las cuales son liberadas desde un foco infeccioso. 2. Diapedesis: capacidad de los globulos blancos de Diapedesis: atravesar la pared de los capilares sin lesionarlos. 3. Mov. Ameboideo: desplazamiento de globulos Ameboideo: blancos por el tejido coenctivo a través de seudópodos 4. Fagocitosis: es el proceso de englobe de sustancias Fagocitosis: extrañas y llevadas dentro de la célula por parte de las enzimas de los lisosomas primarios
1 4 2 3
HEMOGRAMA DE SCHILLING En un frotis de sangre coloreado, se encuentran 100 leucocitos y determina qué porcentaje corresponde a cada tipo de leucocitos. En el adulto normal, se puede considerar como normal Metamielo citos Neutrofilos Eosinof Basof Abast. Segme. 0% 1 -4% 40 - 1 -4% 0 -4% 60% Linf Monocito 2040% 4 -8%
CLASES DE GLOBULOS BLANCOS • 1. 2. 3. Granulocitos: Neutrófilos. Eosinófilos. Basófilos. • Agranulocitos: 1. Linfocitos: • T • B • NK 2. Monocitos.
GLOBULOS BLANCOS GRANULOCITOS
NEUTRÓFILO • 1 era línea de defensa del organismo. • Origen: M. O. R. (Por neutropoyesis aprox. 10 días) • Tamaño: 10 -12 um • Número: 3000 a 6000/ml • Forma: Redonda.
NEUTRÓFILO ABASTONADO • Son los neutrófilos jóvenes, presentan el núcleo el banda. Su valor es 0 -4%. – Desviación Izquierda: significa que hay un aumento de estas células en sangre periférica. Ejm: leucemias, infecciones graves. – Desviación Derecha: el núcleo de los segmentados presenta hipersegmentación. Ejm: deficiencia de vitamina B 12
NEUTRÓFILO SEGMENTADO • Es el neutrófilo maduro presenta un núcleo lobulado en 3 o 4 partes. Los segmentados de mujeres se presentan un pequeño apéndice que sobresale de uno de lo lóbulos en forma de palillo de tambor (corpúsculo de BARR)
NEUTRÓFILO-SEGMENTADO FUNCIONES • Constituyen la primera linea de defensa contra las infecciones bacterianas realizando la “fagocitosis”. • Los gérmenes fagocitados se encuentran en el interior de unas vesículas (fagosomas), luego se adhiren los granulos azurófilos (lisozima, mieloperoxidasa, fosfatasa ácida). Y granulos específicos(fosfatasa alcalina, lactoferrina, fagocitinas) para verter su contenido y matar a las bacterias.
EOSINÓFILOS • Son células acidófilas • Glóbulos blancos granulosos • Origen: MOR (eosinopoyesis) • Tamaño: 9 a 12 um • Número: 200 a 400/ml
EOSINÓFILOS
EOSINÓFILO-FUNCIONES • Fagocitan el complejo Ag-Ac. • Liberan histamina participando en el proceso de alergia. • Contienen profibrinolisina (sust. que disuelven los coágulos). • Aumentan en infecciones parasitarias y en procesos alérgicos severos.
BASÓFILOS • Son glóbulos blancos granulosos. • Origen: MOR (granulopoyesis) • Tamaño: 10 -14 um • Numero: 10 -100/ml • Presenta un citoplasma con garnulos que contiene histamina, heparina, sustancia quimiotactica del eosinófilo, kalicreina, factoe activador de plaquetas.
BASÓFILO-FUNCIONES • Participa en los procesos de alergia. • Gracias a la heparian participa en la anticoagulación. Nota: los mastocitos son celulas basofilas del tejido Nota: conectivo estos se encuentran en los tejidos especiales de los pulmones, el tejido, linfoide, y las capas submucosas del tracto digestivo. No descienden de los basófilos.
GLOBULOS BLANCOS AGRANULOCITOS
MONOCITOS Histiotocitos, Cla ragiocra , poliblasto G. B joven grande(mayor tamaño), cuando regresa a T. Conectivo se transforma en macrófago (f: fagocitosis, costituye 2 da. Línea de Defensa clas de organismo) Tamaño: 12 a 20 Número: 200 a 700 monocitos por mm 3 sangre (4 al 8 % de leucocitos) Alteraciones M: TBC, Infección , Cronica, Tifoidea. M: Brucelosis , Paludismo , Enf. de Hodkin.
LINFOCITOS • G. B agranulosos, se localizan en sangre y linfa • Origen: M. O. R. Ganglios linfaticos, bazo, timo. etc. LINFOCITOS • Tamaño: 7 - 12 UM • Número: 1, 500 a 3, 000/ML (30% del total de G. B). • TIPOS DE LINFOCITOS: – LINFOCITOS T – LINFOCITOS B – LINFOCITOS NK
LINFOCITOS T • LINFOCITOS T: Son los mas abundantes. • Timodependiente • Se origina en M: O: R y madura en el timo. • Realiza “inmunidad celular”, ya que se pone en contacto directo con los antígenos , pero este contacto se realiza previa presentación del antigeno por medio de clas presentadores (macrófago , linfocito ) • Rechaza órganos transplantados
LINFOCITO B • Linfocito B (10 – 15%) • Timoindependiente , bursodependiente • Se origina de la bolsa de fabricio (aves) en intestino, M. Ósea roja , órganos linfoides (ganglios, bazo, timo, amígdalas) hígado (vida intrauterina ) • Origina : Clas blásticas clas pironinofilas clas plasmáticas (presenta Ac) • Realiza “inmunidad humonal” liberando Ac. Que destruyen a los Ag.
LINFOCITO NK • Linfocito NK (Natural killer o asesino natural) • Destruye directamente a clas extañas (clas tumorales ), clas de trasplantes mediante perforinas • Alteraciones: L : infecciónes crónicas , , sarampión, paperas , sificilis L : Enf. de Hodgkin, stress, traumatismos.
COAGULACIÓN DE LA SANGRE • Es el proceso por el cual se detiene totalmente una hemorragia. Se lleva a cabo en 3 etapas: formación del activador de la protrombina, formación del activador de la protombrina, formación de la trombina formación de la fibrina. Existen 2 vías para lograr la coagulación(vía intrínseca y extríseca ) , las cuales al final lograrán la transformación del fibrinógeno en fibrina.
VÍAS DE LA COAGULACIÓN
FACTORES DE LA COAGULACIÓN
GRUPOS SANGUÍNEOS • Es cualquier sistema bien definido de aglutinógenos. • Existen en la membrana celular de eritrocitos unas glucoproteínas llamadas antígenos o aglutinógenos que están determinados genéticamente. Es debido a la presencia de estos aglutinógenos que podemos clasificar a los individuos en grupos sanguíneos. • Las aglutininas anti. A y anti. B son anticuerpos naturales, ya que nacen con el individuo y son del tipo Ig. M. • Existen otros sistemas menos importantes como : sistema MNS, Lutherans, kell, Duffy, kidd, Diego , P, Xg , Auberger , Colton, Dombrek , lewis , Scianna, Sid
SISTEMA ABO
SISTEMA RHESUS(Rh)